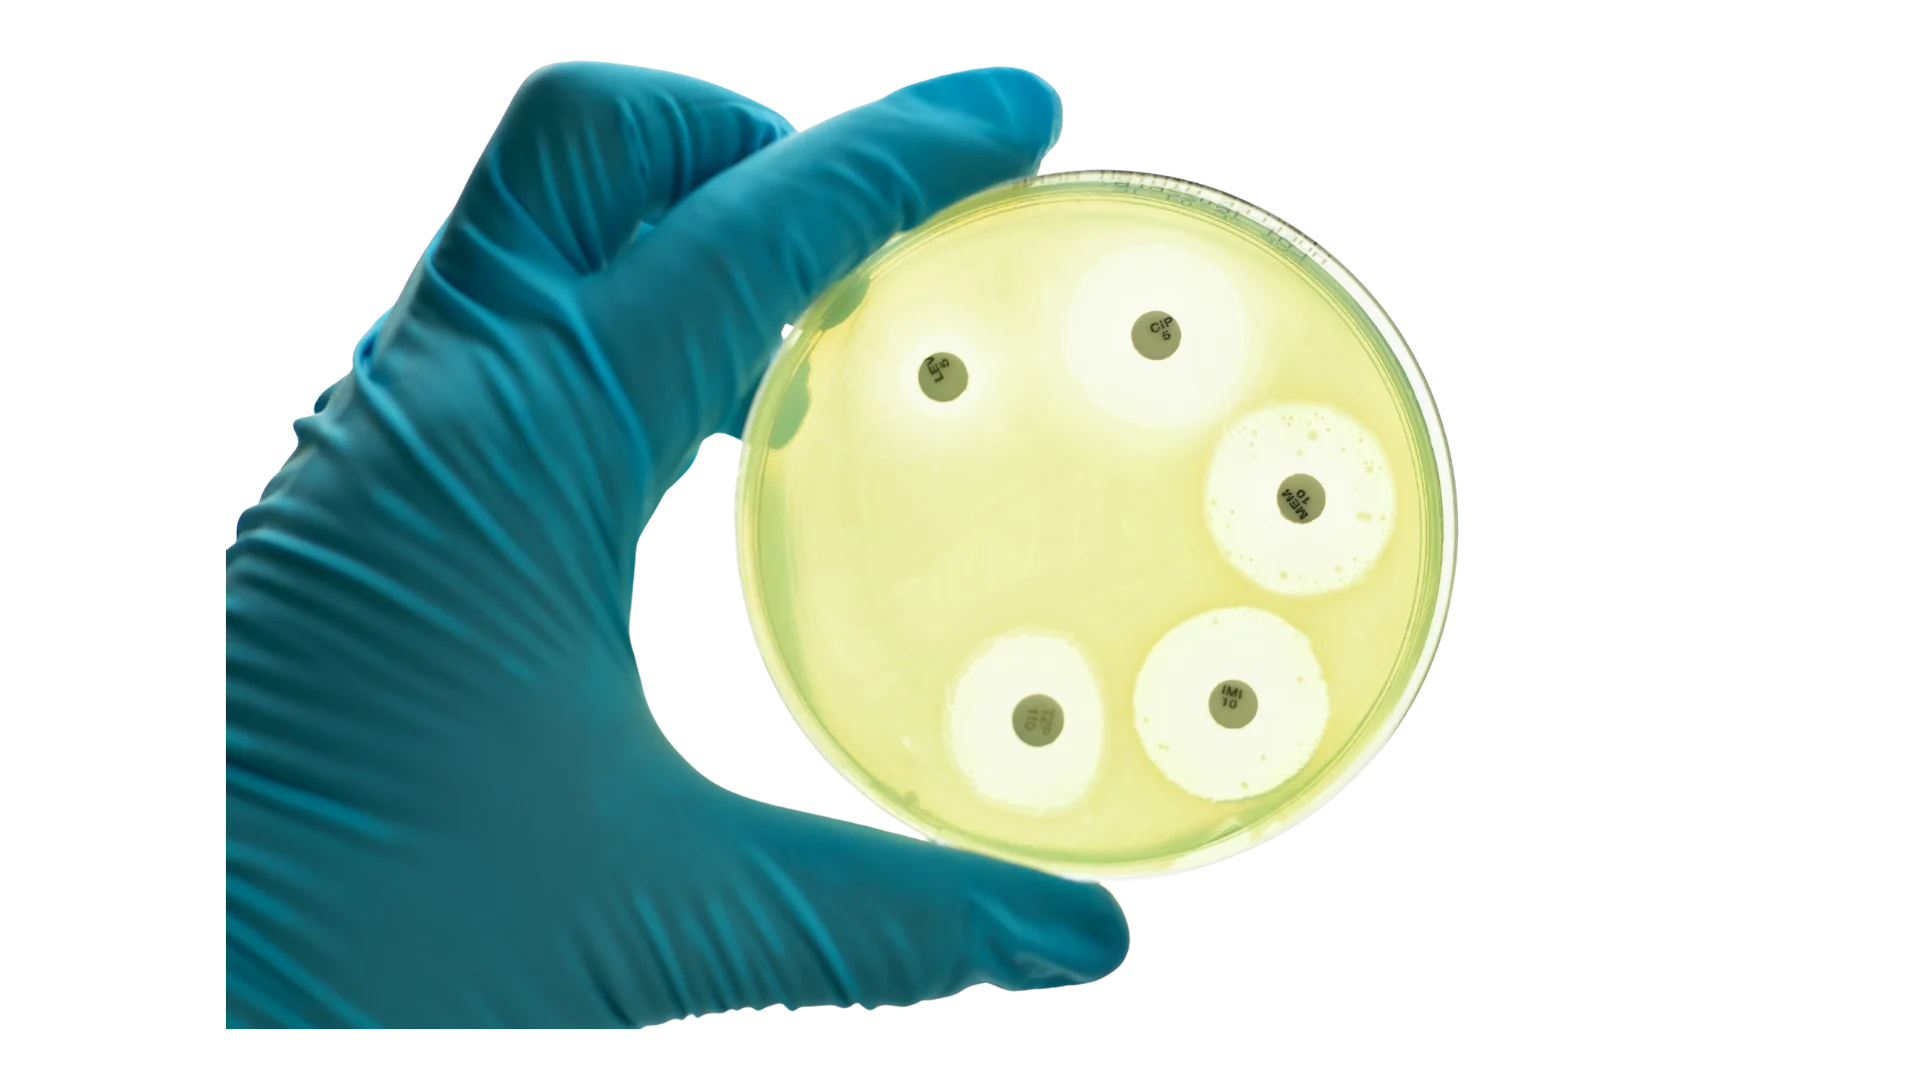
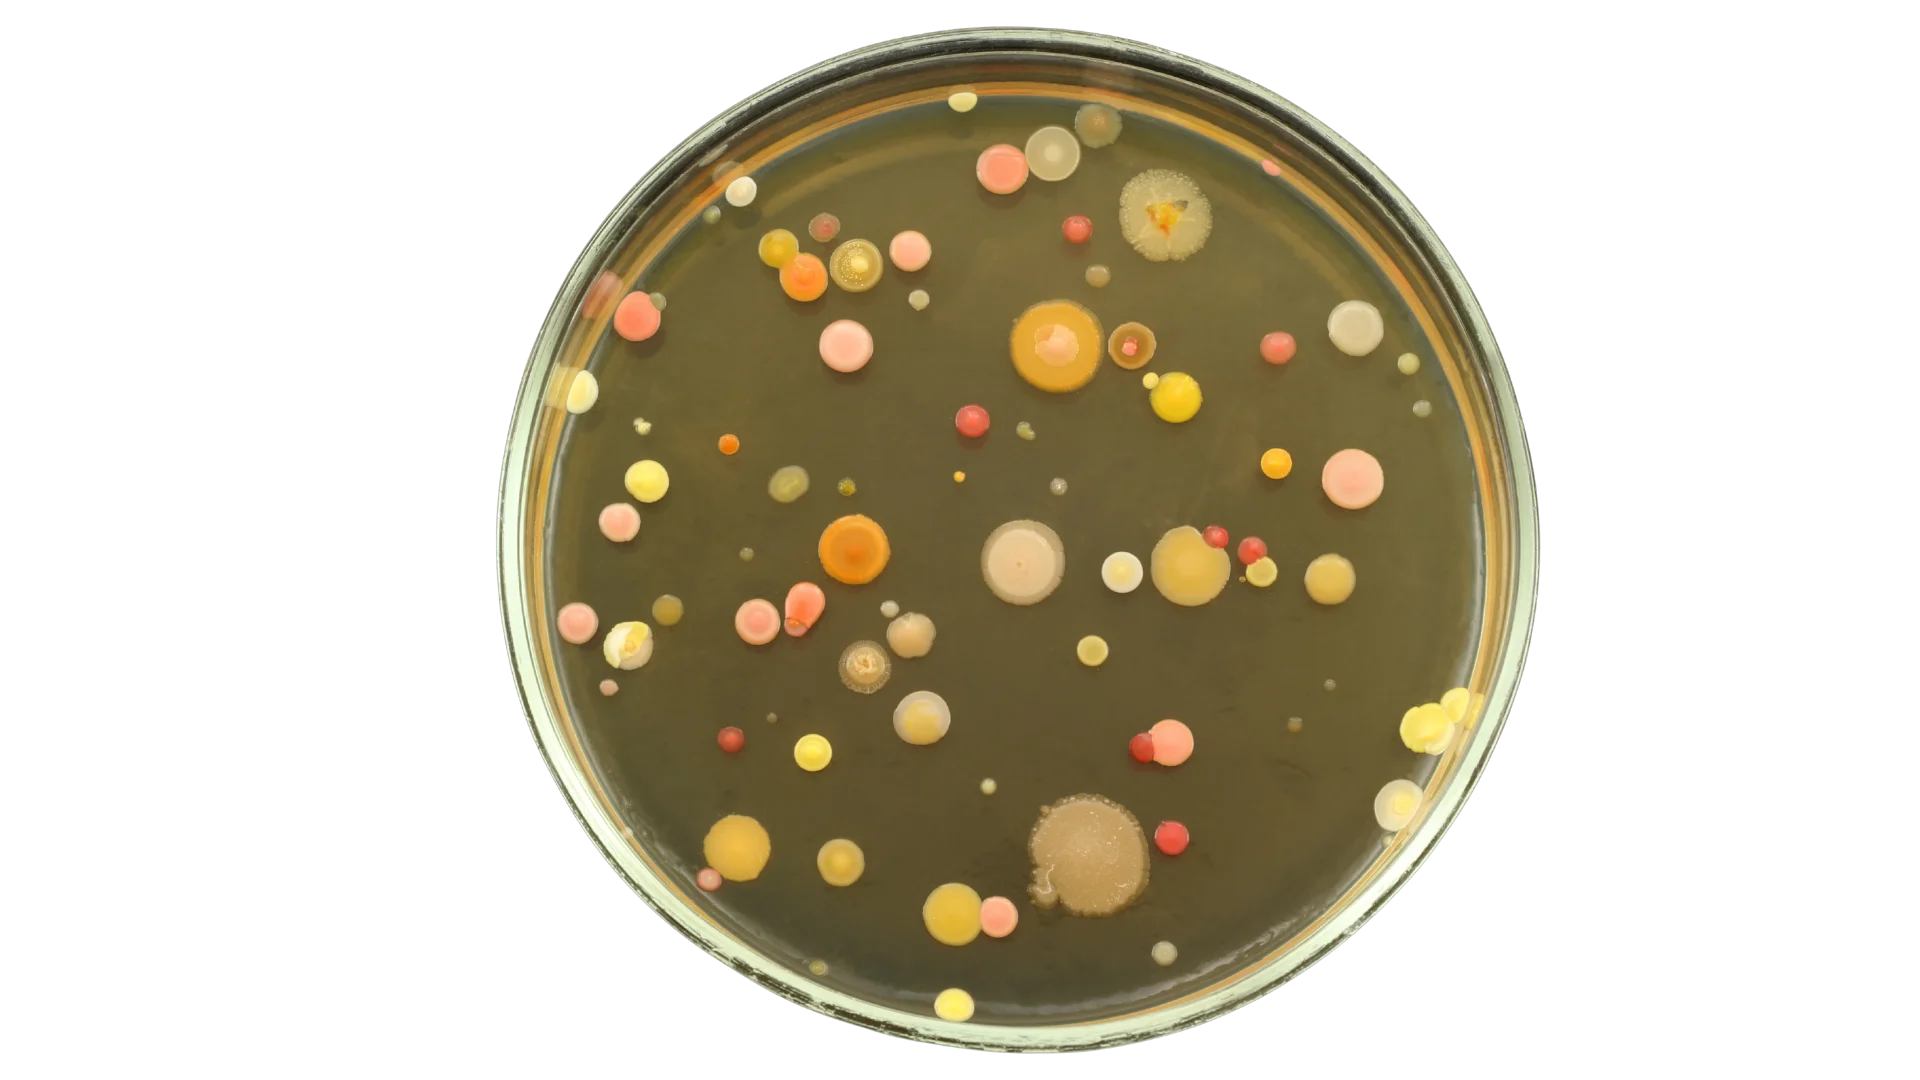
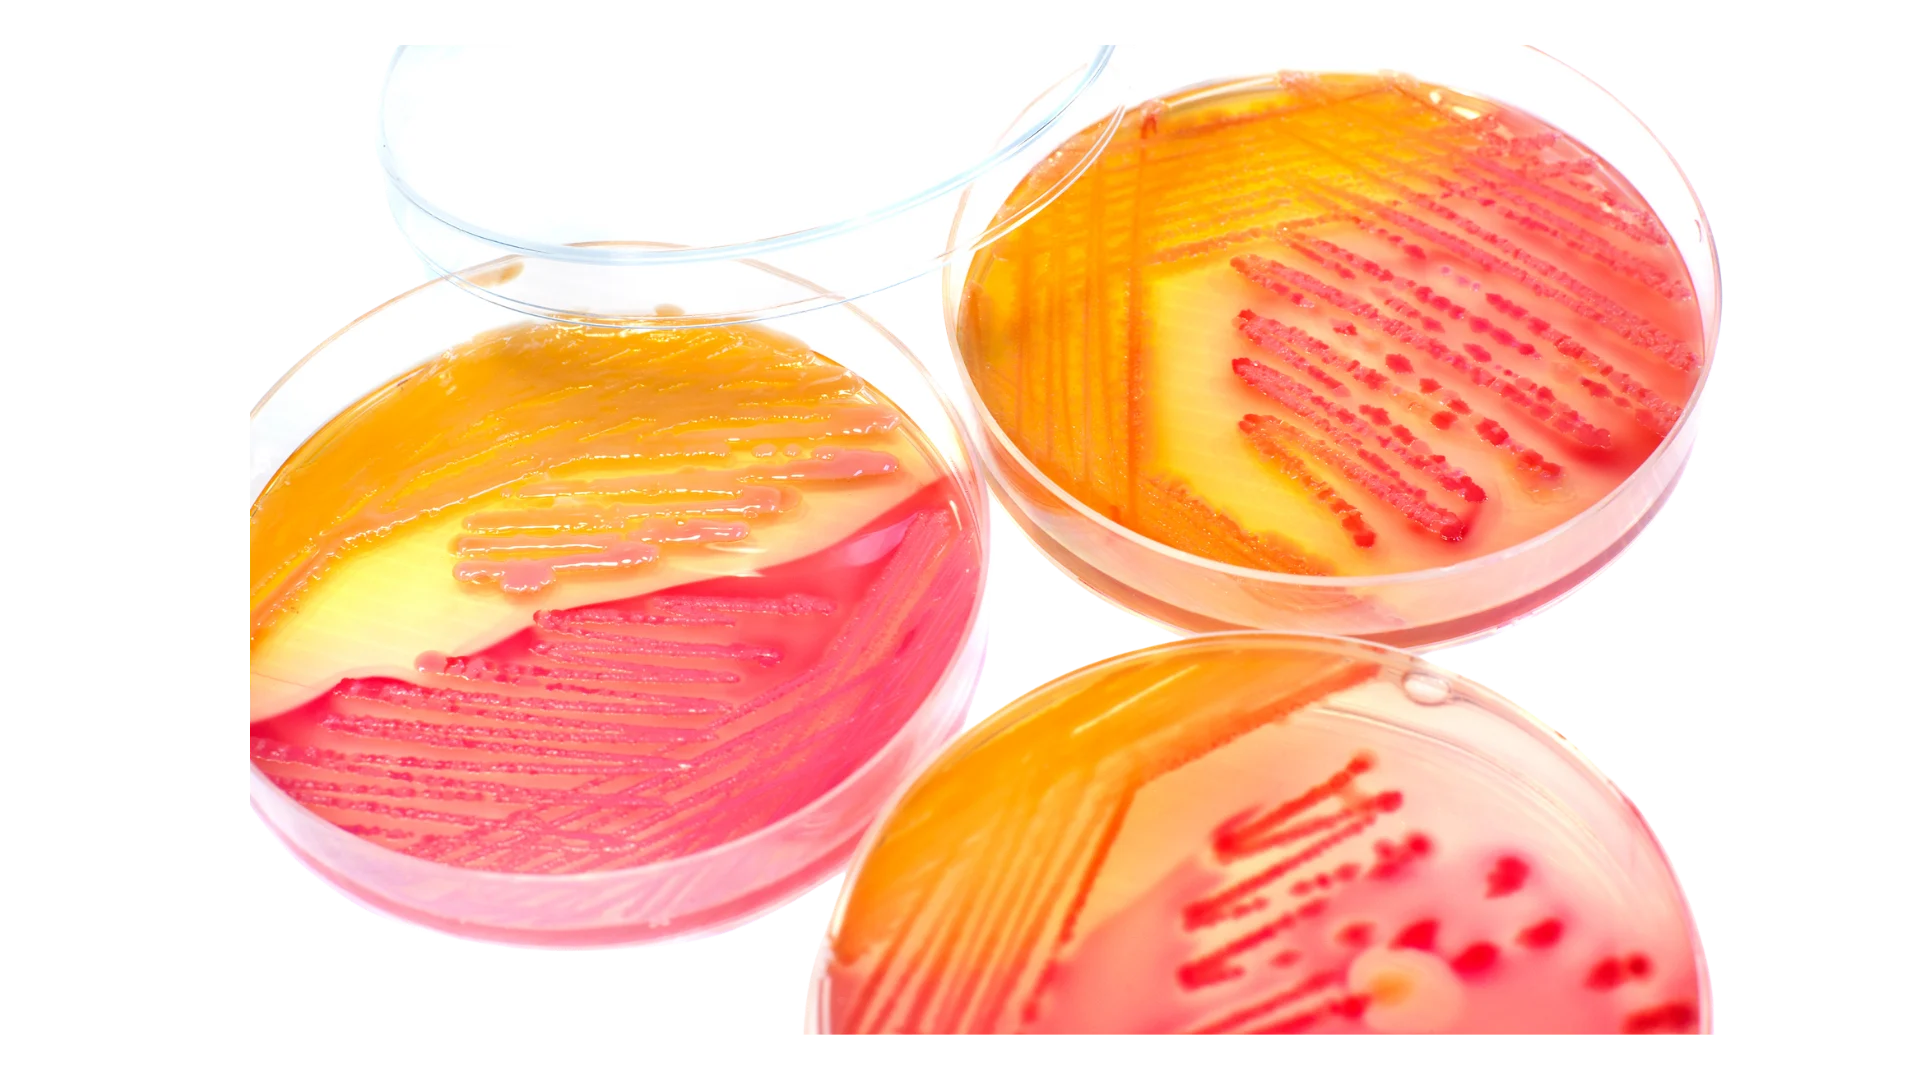

บริการทดสอบความปลอดภัยและฤทธิ์ทางชีวภาพสำหรับผลิตภัณฑ์สุขภาพ เครื่องมือแพทย์ เครื่องสำอาง สมุนไพร และเคมีภัณฑ์ที่ใช้ในครัวเรือน
- TBES ดำเนินงานภายใต้ระบบมาตรฐานสากล OECD GLP (GLP No. 36/68) ซึ่งให้บริการทดสอบความปลอดภัยของผลิตภัณฑ์สุขภาพตามวิธี OECD Test Guidelines และทดสอบความเข้ากันได้ทางชีวภาพ (Biocompatibility) ของเครื่องมือแพทย์ ตามชุดมาตรฐาน ISO 10993 เพื่อให้ได้ข้อมูลที่พร้อมขึ้นทะเบียนผลิตภัณฑ์ทั้งในประเทศและต่างประเทศ
- นอกจากนี้ยังให้บริการทดสอบฤทธิ์ทางชีวภาพ สำหรับผลิตภัณฑ์เครื่องสำอาง สมุนไพร และเคมีภัณฑ์ที่ใช้ในครัวเรือน
TBES ใช้วิธีทดสอบในระบบเซลล์เพาะเลี้ยงละเนื้อเยื่อสามมิติ (2D cell culture and 3D tissues) ระบบจุลชีววิทยา (Microbiology) และระบบทางเคมี (In chemico) ที่ไม่ต้องใช้สัตว์ทดลอง ซึ่งสอดคล้องกับข้อกำหนดและหลักปฏิบัติสากล ภายใต้ห้องปฏิบัติการ BSL2 และเครื่องมือที่ทันสมัยครบครัน มั่นใจด้วยระบบคุณภาพ และทีมผู้เชี่ยวชาญที่พร้อมให้คำปรึกษา
บริการทดสอบของ TBES
TBES พร้อมให้บริการทดสอบที่ได้มาตรฐาน แก่ผู้ประกอบการภาคอุตสาหกรรม เพื่อให้ได้ผลิตภัณฑ์ที่มีคุณภาพและความปลอดภัย

การทดสอบความเข้ากันได้ทางชีวภาพของเครื่องมือแพทย์
- การประเมินทางชีวภาพของเครื่องมือแพทย์ – ISO 10993-1
- ความเป็นพิษต่อเซลล์ (Cytotoxicity) – ISO 10993-5
- การระคายเคืองต่อผิวหนัง (Skin irritation) – ISO 10993-23
การทดสอบความปลอดภัยสำหรับผลิตภัณฑ์สุขภาพ
- การระคายเคืองต่อผิวหนัง (Skin irritation) – OECD 439
- การกัดกร่อนผิวหนัง (Skin corrosion) – OECD 431
- การระคายเคืองต่อดวงตา (Eye irritation) – OECD 492, OECD 492B
- ความเป็นพิษเมื่อกระตุ้นด้วยแสงยูวี (Phototoxicity) – OECD 432
- ความไวต่อการกระตุ้นการแพ้ทางผิวหนัง (Skin sensitization) – OECD No. 497: OECD 442C, OECD 442D, OECD 442E
- ความเป็นพิษเมื่อกระตุ้นด้วยแสงยูวี (Phototoxicity) – OECD 101, OECD 432
- การเกิดอนุมูลอิสระเมื่อกระตุ้นด้วยแสงยูวี (ROS assay for photoreactivity) – OECD 495
- ฤทธิ์ก่อกลายพันธุ์ (Mutagenicity) – OECD 471
บริการทดสอบฤทธิ์ทางชีวภาพ
- ฤทธิ์ต้านอนุมูลอิสระ (Anti-oxidant activity) – วิธีทดสอบ DCF, DPPH, ABTS, FRAP, ORAC
- ฤทธิ์ยับยั้งการสร้างเม็ดสีของผิวหนัง (Anti-melanogenesis)
- ฤทธิ์ยับยั้งเอนไซม์ Tyrosinase
- ฤทธิ์การสมานแผล (Wound healing)
- ฤทธิ์การยับยั้งเซลล์มะเร็ง (Anti-cancer activities) – Apoptotic cell death, Cell proliferation, Cell cycle arrest ด้วยวิธี FACS analysis
- ฤทธิ์กระตุ้นการสร้างไฮยาลูรอนิค (Hyaluronan Production Assay)
- ฤทธิ์กระตุ้นการสร้าง Collagen Type I (Collagen Type I Production Assay)
- ฤทธิ์การยับยั้งการสลายคอลลาเจน (MMP-1 Expression Assay
บริการทดสอบทางจุลชีววิทยา
Antibacterial testing
- การทดสอบฤทธิ์ฆ่าเชื้อจุลชีพบนพื้นผิวของวัสดุ – JIS Z 2801, ISO 22196

- การทดสอบประสิทธิภาพการต้านเชื้อจุลชีพในผลิตภัณฑ์สิ่งทอ- AATCC 147, AATCC 100, ASTM E2149 และ JIS L 1902
- การทดสอบประสิทธิภาพสารกันเสียในเครื่องสำอาง – ISO 11930
- การทดสอบประสิทธิภาพสารกันเสียในผลิตภัณฑ์ยา เครื่องสำอาง และผลิตภัณฑ์สุขภาพ – USP <51>
- การประเมินฤทธิ์ต้านแบคทีเรียด้วยวิธีการแพร่กระจายผ่านแผ่นยา (Disk Diffusion) และการหาค่า Minimum Inhibitory Concentration (MIC) – CLSI M02-A11, CLSI M07-A9
- การทดสอบประสิทธิภาพสารต้านจุลชีพด้วยวิธี Time-Kill – ASTM E2315
- การทดสอบฤทธิ์ต้านแบคทีเรียของสารดูดซับน้ำชนิด absorbent polyacrylate – JIS S 0252
Disinfectant testing
- การทดสอบประสิทธิภาพผลิตภัณฑ์ฆ่าเชื้อชนิดฉีดพ่นอัดแก๊ส และฉีดพ่นธรรมดาบนพื้นผิว – AOAC 961.02
- การทดสอบประสิทธิภาพน้ำยาฆ่าเชื้อบนพื้นผิว (Use-Dilution Method) – AOAC 955.14, AOAC 955.15, AOAC 964.02
- การทดสอบประสิทธิภาพการฆ่าเชื้อในอากาศภายในห้องด้วยระบบพ่นอัตโนมัติ – BS EN 17272
- การทดสอบประสิทธิภาพของผลิตภัณฑ์ฆ่าเชื้อบนพื้นผิว- BS EN 13697
- การทดสอบประสิทธิภาพการฆ่าแบคทีเรียของสารฆ่าเชื้อ – BS EN 1276
Microbial Enumeration in Products
- การตรวจวิเคราะห์จำนวนจุลินทรีย์ในผลิตภัณฑ์สุขภาพ เครื่องสำอาง อาหารเสริมและยา – USP <61>, USP <62>
- การตรวจวิเคราะห์จุลินทรีย์ในแผ่นเช็ดทำความสะอาดและแผ่นมาสก์ – ISO 21322